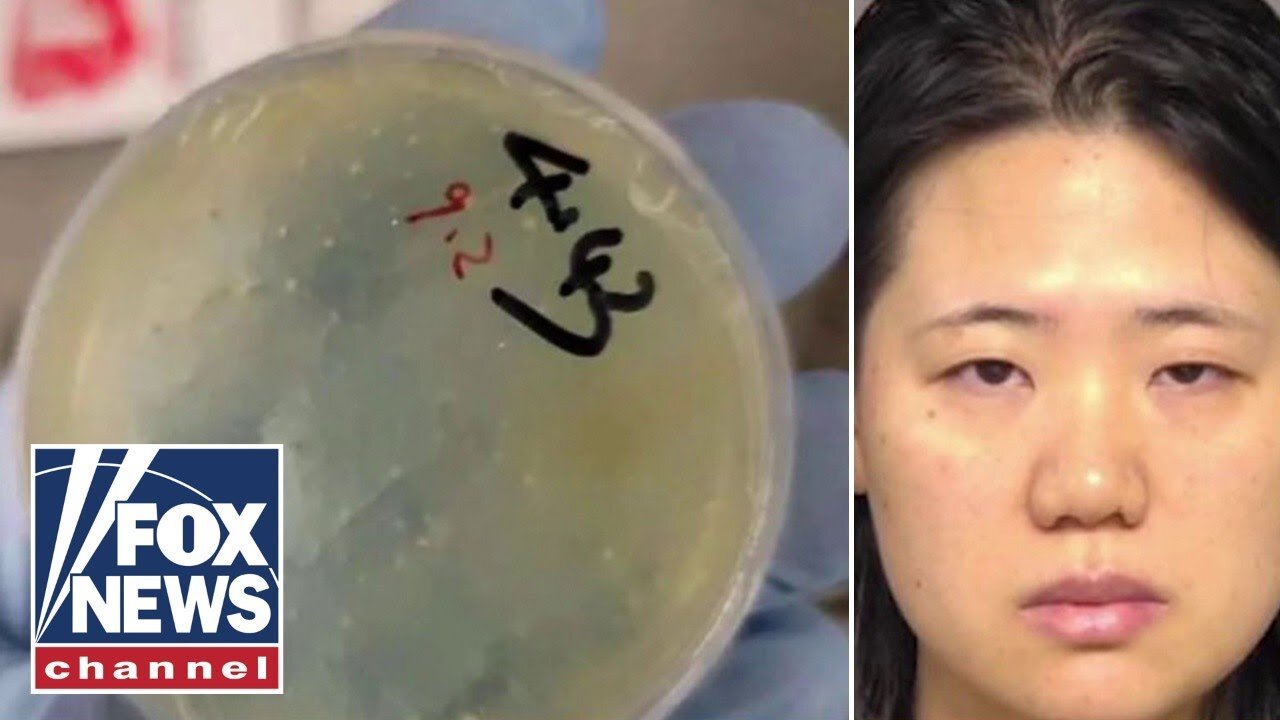

Premium Only Content
_ALARMING__ Third Chinese national accused of smuggling bio weapons in latest threat to US security
Former assistant U.S. attorney Andy McCarthy joins 'America's Newsroom' to discuss another Chinese national being arrested for allegedly smuggling bio weapons in the country and California Governor Gavin Newsom suing President Donald Trump. #trump #china #usnews #news #foxnews
Subscribe to Fox News! https://bit.ly/2vBUvAS
Watch more Fox News Video: http://video.foxnews.com
Watch Fox News Channel Live: http://www.foxnewsgo.com/
FOX News Channel (FNC) is a 24-hour all-encompassing news service delivering breaking news as well as political and business news. The number one network in cable, FNC has been the most-watched television news channel for 18 consecutive years. According to a 2020 Brand Keys Consumer Loyalty Engagement Index report, FOX News is the top brand in the country for morning and evening news coverage. A 2019 Suffolk University poll named FOX News as the most trusted source for television news or commentary, while a 2019 Brand Keys Emotion Engagement Analysis survey found that FOX News was the most trusted cable news brand. A 2017 Gallup/Knight Foundation survey also found that among Americans who could name an objective news source, FOX News was the top-cited outlet. Owned by FOX Corporation, FNC is available in nearly 90 million homes and dominates the cable news landscape, routinely notching the top ten programs in the genre.
Watch full episodes of your favorite shows
The Five: https://www.foxnews.com/video/shows/the-five
Special Report with Bret Baier: https://www.foxnews.com/video/shows/special-report
Jesse Watters Primetime: https://www.foxnews.com/video/shows/jesse-watters-primetime
Hannity: https://www.foxnews.com/video/shows/hannity
The Ingraham Angle: https://www.foxnews.com/video/shows/ingraham-angle
Gutfeld!: https://www.foxnews.com/video/shows/gutfeld
Fox News @ Night: https://www.foxnews.com/video/shows/fox-news-night
Follow Fox News on Facebook: https://www.facebook.com/FoxNews/
Follow Fox News on Twitter: https://twitter.com/FoxNews/
Follow Fox News on Instagram: https://www.instagram.com/foxnews/
-
11:09
Fox News
8 hours agoPerino: Don't they realize this HELPS Trump?
7 -
10:28
BlabberingCollector
11 hours agoAsk Blabs, Episode 5 | Answering Your Wizarding World Related Questions
1.17K -
18:09
Forrest Galante
5 days agoI Survived 24 Hours In The World's Deadliest Jungle
180K30 -
LIVE
Lofi Girl
2 years agoSynthwave Radio 🌌 - beats to chill/game to
181 watching -
2:15:09
Badlands Media
15 hours agoOnlyLands Ep. 27: Power Hour Hangover, Trump’s Wartime Shift, and Portland in Flames
104K23 -
22:21
DeVory Darkins
5 hours ago $14.96 earnedRioters attack Portland ICE Facility as Democrats make shocking admission
14.3K75 -
2:06:06
TimcastIRL
8 hours agoTrump DOJ Announces INTERVENTION In Portland Over Nick Sortor Arrest | Timcast IRL
228K368 -
6:53:58
SpartakusLIVE
9 hours ago#1 All-American HERO with LUSCIOUS hair and AVERAGE forehead brings Friday Night HYPE
65.1K7 -
3:06:43
Laura Loomer
7 hours agoEP147: Islamic Terror EXPLODES In The West After UK Synagogue Attack
49.1K43 -
1:02:50
Flyover Conservatives
13 hours agoEric Trump: America’s Most Subpoenaed Man SPEAKS OUT! | FOC Show
43K12